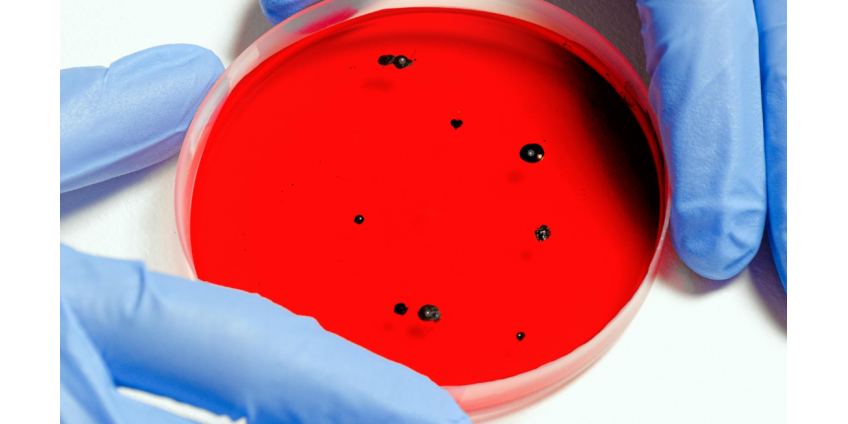
В Роспотребнадзоре прокомментировали риск завоза африканского заболевания В Роспотребнадзоре прокомментировали риск завоза африканского заболевания

Теги:лихорадка
В округе Лос-Анджелес зарегистрирован первый местный случай лихорадки денге в 2025 году
В округе Лос-Анджелес подтверждён первый в этом году случай локально приобретённой лихорадки денге.
ВОЗ заявила о летальных случаях от лихорадки Марбург
Зафиксировано восемь летальных случаев в связи с заболеванием считающимся неизлечимым вирусом Марбург в Танзании.
Подтверждён пятый случай лихорадки денге в округе Лос-Анджелес
В среду власти здравоохранения округа Лос-Анджелес сообщили о пятом локально приобретённом случае лихорадки денге, на этот раз у жителя Эль-Монте.
Школьника парализовало после укуса комара
Старшеклассник из Хейзелвуда (штат Миссури, США) заразился лихорадкой Западного Нила после укуса комара.
Округ Лос-Анджелес сообщает о первом образце вируса Западного Нила в 2024 году
В субботу официальные лица сообщили, что в округе Лос-Анджелес была подтверждена проба комаров, зараженных вирусом лихорадки Западного Нила.
В Роспотребнадзоре прокомментировали риск завоза африканского заболевания
В России отсутствуют риски завоза и распространения африканской лихорадки Ласса.
Вспышка попугайной лихорадки в Европе унесла жизни пяти человек
В странах Европы наблюдается рост случаев заболевания людей орнитозом, который также называют попугайной лихорадкой.
В Индии сообщили о резкой вспышке лихорадки денге
В Нью-Дели резко растет число случаев лихорадки денге, вирусного заболевания, вызывающего в тяжелых случаях геморрагический шок.
В «Векторе» оценили вероятность вспышки конго-крымской лихорадки
В России нет условий для вспышки заболеваемости конго-крымской геморрагической лихорадкой.